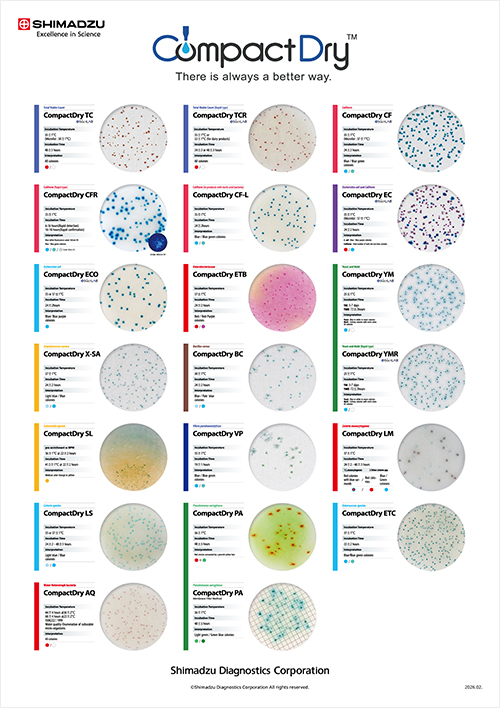
Poster

International Business
International Business
Applying testing agent know-how accumulated in Japan, we are engaged in the provision of antibodies on an OEM basis in our clinical diagnostic agent business, and identifying needs in individual countries to globally promote and sell our mainstay CompactDry™ product in our industrial diagnostics business.
Global Performance of the Clinical Diagnostic Agent Business

Global Performance in the Industrial Diagnostics Business

CompactDry™ EC

CompactDry™ TC
CompactDry Laboratory Poster
(For incubation conditions and colony interpretation)
Treatises / Media
Treatises
CompactDry™ BC: "Japanese Journal of Food Microbiology"
※Japanese Journal of Food Microbiology (n.d.). Japan Science and Technology Agency [JST] Website, Retrieved April 5, 2021,
from https://www.jstage.jst.go.jp/browse/-char/en
Product Videos
CompactDry™ Global Promotion Video
CompactDry™ End-User Manual
CompactDry™ Operation Manual
CompactDry™ TIPS for Interpretation
CompactDry™ Illustration Manual
International Certifications
To ensure reliability, Shimadzu Diagnostics has gained certifications from the AOAC in the U.S. and MicroVal and NordVal in the EU. In Japan, our analytical approaches have been included in the Standard Methods of Analysis in Food Safety Regulation.
International Food Safety Standards (International Certifications)

CompactDry™ International Certification Map

Global Supply Chain
Through our global supply chain, we are promoting safety and peace of mind for food manufacturers.
Global Supply Chain

Cases of How Our Products Are Used
CompactDry™, our mainstay product, enjoys broad usage outside Japan because of its high quality and its unique ability to be stored at room temperature.
Real-time Coliform Detection
We help governments of countries receiving UNICEF support by providing technical assistance related to water-quality safety planning and monitoring.
CompactDry™ International Performance and Evaluations(17.4MB)Support for a Daily Essential (Water-quality testing)
CompactDry™, our mainstay product, enjoys broad usage outside Japan because of its high quality and its unique ability to be stored at room temperature.
CompactDry™ International Performance and Evaluations (17.4MB)Bangladesh 2012-13 MICS Final Report
In Bangladesh, the drinking-water standard calls for the detection of no E. Coli bacteria in a sample of 100mL of water. This report describes testing performed with CompactDry™ EC.
Official UNICEF/MICS
Website_Bangladesh 2012-13 MICS Final Report(→P104)
http://mics.unicef.org/news_entries/15